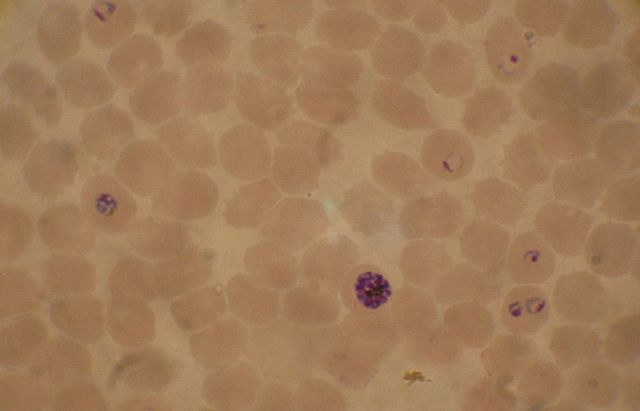
Image:Plasmodium falciparum 02.jpg

From Wikipedia, the free encyclopedia
 Size of this preview: 640 × 411 pixels
Size of this preview: 640 × 411 pixels Full resolution (1,159 × 745 pixels, file size: 96 KB, MIME type: image/jpeg)
 |
This is a file from the Wikimedia Commons. The description on its description page there is shown below.Commons is a freely licensed media file repository. You can help.
|
| Description |
English: Bloodsmear of a P.falciparum culture (K1 strain). Ring stages, Schizont in the lower centre, Trophozoite on the left.
|
| Source |
Transferred from en.wikipedia
(Original text : picture taken by myself.) |
| Date |
Created 5. Oct. 2006 |
| Author |
Original uploader was Lukas.S at en.wikipedia
(Original text : Lukas 05:24, 5 October 2006 (UTC)) |
Permission
( Reusing this image) |
Released into the public domain (by the author).
|
License information
 |
This image has been (or is hereby) released into the public domain by its author, Lukas.S at the wikipedia project. This applies worldwide.
In case this is not legally possible:
Lukas.S grants anyone the right to use this work for any purpose, without any conditions, unless such conditions are required by law. |
Original upload log
The original description page is/was here. All following user names refer to en.wikipedia.
- 2006-10-05 05:19 Lukas.S 1159×745×8 (97912 bytes) Bloodsmear of a P.falciparum culture (K1 strain). Ring stages, Schizont in the lower centre, Trophozoite on the left.
File history
Click on a date/time to view the file as it appeared at that time.
|
|
Date/Time |
Dimensions |
User |
Comment |
| current |
11:28, 11 May 2008 |
1,159×745 (96 KB) |
File Upload Bot (Magnus Manske) |
|
File links
The following pages on Schools Wikipedia link to this image (list may be incomplete):